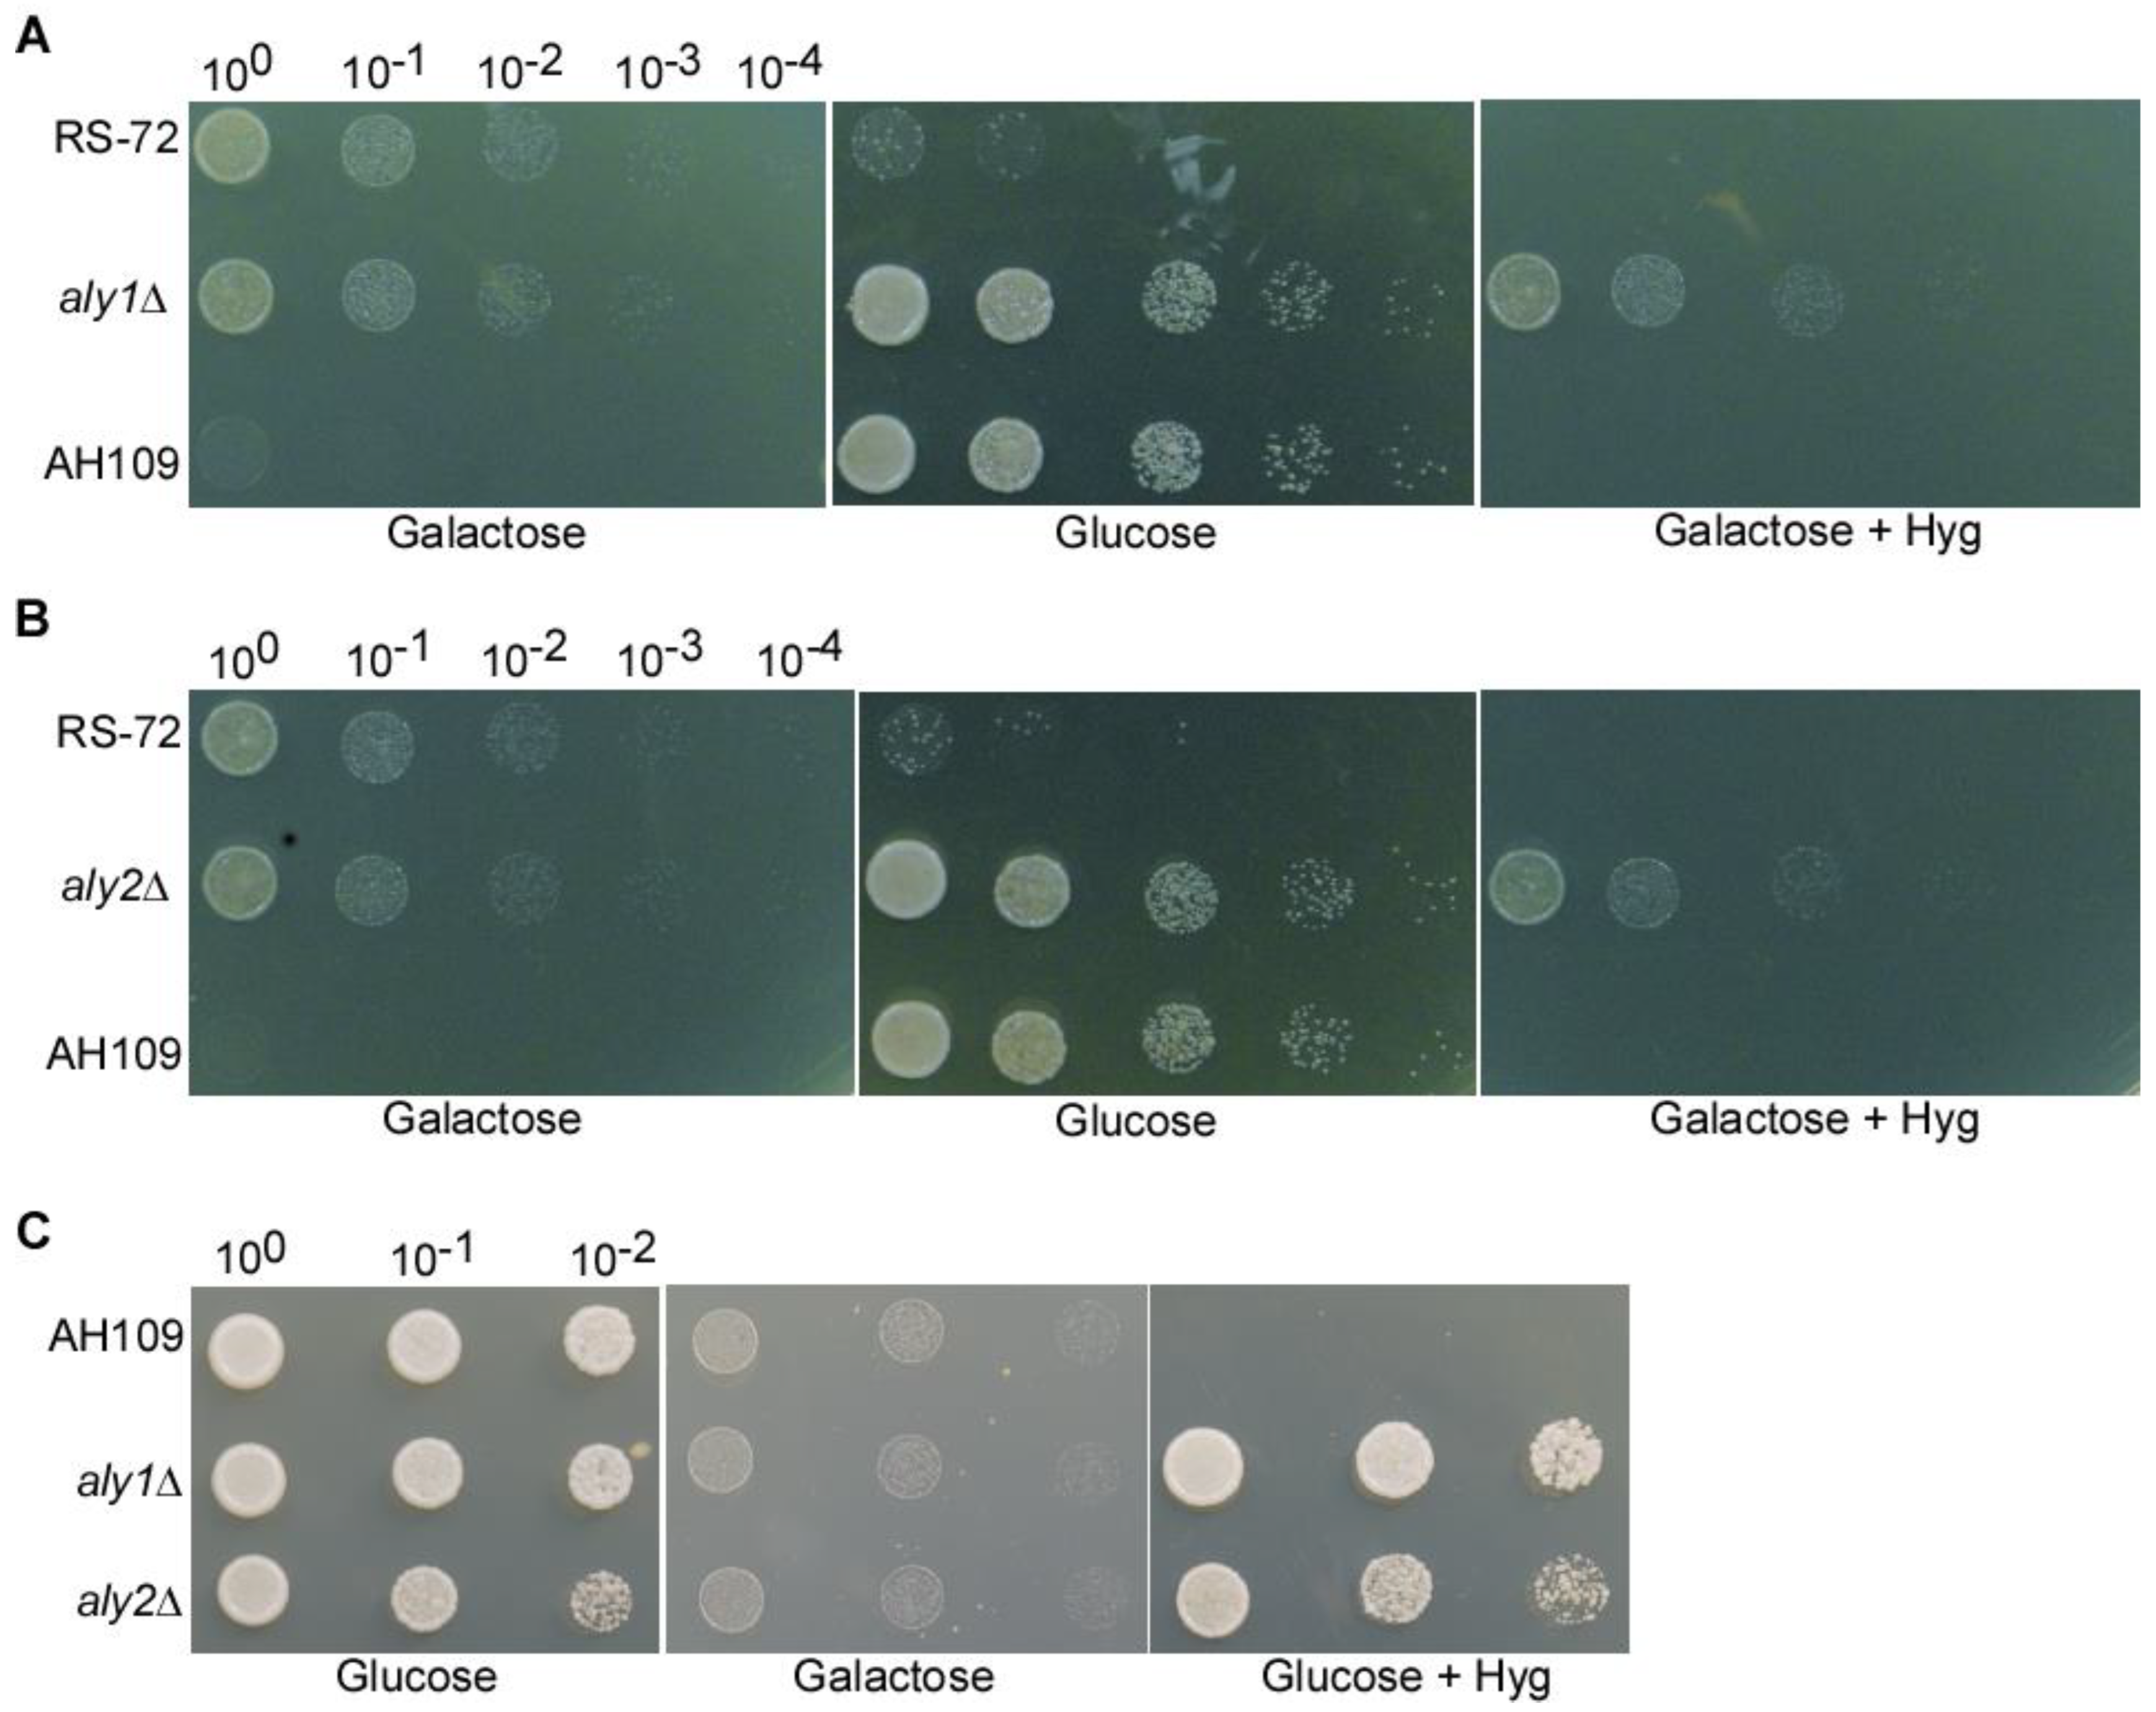
Preprints 90475 g002

Submitted:
14 November 2023
Posted:
14 November 2023
You are already at the latest version
Abstract
Keywords:
1. Introduction
2. Results
2.1. Screening for new components possibly involved in cytosolic pH homeostasis
2.2. The loss of Aly1 and Aly2 function can rescue growth of yeast cells with reduced Pma1 activity
2.3. The loss of Aly1 or Aly2 function promotes H+ extrusion in yeast cells with reduced Pma1 activity
2.4. The loss of Aly1 or Aly2 function recovers cytosolic pH in yeast cells with reduced Pma1 activity
3. Discussion
4. Materials and Methods
4.1. Yeast strains
4.2. Aly1 and Aly2 deletion assay
4.3. Suppressor screening assay
4.4. SNARF-AM staining assay
Author Contributions
Funding
Declaration of interests
References
- Deprez, M.A., Eskes, E., Wilms, T., Ludovico, P., and Winderickx, J. (2018). pH homeostasis links the nutrient sensing PKA/TORC1/Sch9 ménage-à-trois to stress tolerance and longevity. Microbial cell 5, 119-136.
- Isom, D.G., Page, S.C., Collins, L.B., Kapolka, N.J., Taghon, G.J., and Dohlman, H.G. (2018). Coordinated regulation of intracellular pH by two glucose-sensing pathways in yeast. J BIOL CHEM 293, 2318-2329. [CrossRef]
- Ramos, S., Balbín, M., Raposo, M., Valle, E., and Pardo, L.A. (1989). The mechanism of intracellular acidification induced by glucose in Saccharomyces cerevisiae. Journal of general microbiology 135, 2413-2422. [CrossRef]
- Eskes, E., Deprez, M.A., Wilms, T., and Winderickx, J. (2018). pH homeostasis in yeast; the phosphate perspective. CURR GENET 64, 155-161. [CrossRef]
- Huang, C., and Chang, A. (2011). pH-dependent cargo sorting from the Golgi. The J BIOL CHEM 286, 10058-10065.
- Mortensen, H.D., Gori, K., Siegumfeldt, H., Nissen, P., Jespersen, L., and Arneborg, N. (2006). Intracellular pH homeostasis plays a role in the NaCl tolerance of Debaryomyces hansenii strains. Appl. Microbiol. Biotechnol. 71, 713-719. [CrossRef]
- Kane, P.M. (2016). Proton Transport and pH Control in Fungi. Adv. Exp. Med. Biol. 892, 33-68.
- Serrano, R. (1983). In vivo glucose activation of the yeast plasma membrane ATPase. FEBS LETT 156, 11-14. [CrossRef]
- Ma, T.Y., Deprez, M.A., Callewaert, G., and Winderickx, J. (2021). Coordinated glucose-induced Ca2+ and pH responses in yeast Saccharomyces cerevisiae. Cell calcium 100, 102479. [CrossRef]
- Lecchi, S., Nelson, C.J., Allen, K.E., Swaney, D.L., Thompson, K.L., Coon, J.J., Sussman, M.R., and Slayman, C.W. (2007). Tandem phosphorylation of Ser-911 and Thr-912 at the C terminus of yeast plasma membrane H+-ATPase leads to glucose-dependent activation. J BIOL CHEM 282, 35471-35481. [CrossRef]
- Saliba, E., Evangelinos, M., Gournas, C., Corrillon, F., Georis, I., and André, B. (2018). The yeast H+-ATPase Pma1 promotes Rag/Gtr-dependent TORC1 activation in response to H+-coupled nutrient uptake. ELIFE 7.
- Tomashevsky, A.A., and Petrov, V.V. (2022). Point mutations in the different domains of the Saccharomyces cerevisiae plasma membrane PMA1 ATPase cause redistribution among fractions of inorganic polyphosphates. J Biomol Structure Dyn 40, 635-647. [CrossRef]
- Lee, Y., Nasution, O., Lee, Y.M., Kim, E., Choi, W., and Kim, W. (2017). Overexpression of PMA1 enhances tolerance to various types of stress and constitutively activates the SAPK pathways in Saccharomyces cerevisiae. Appl. Microbiol. Biotechnol. 101, 229-239. [CrossRef]
- Yoon, S.Y., Jang, E., Ko, N., Kim, M., Kim, S.Y., Moon, Y., Nam, J.S., Lee, S., and Jun, Y. (2022). A Genome-Wide Screen Reveals That Endocytic Genes Are Important for Pma1p Asymmetry during Cell Division in Saccharomyces cerevisiae. Int. J. Mol. Sci. 23. [CrossRef]
- Tung, T.T., and Nielsen, J. (2022). Drug Discovery and Development on Pma1, Where Are We Now? A Critical Review from 1995 to 2022. CHEMMEDCHEM 17, e202200356.
- Wilms, T., Swinnen, E., Eskes, E., Dolz-Edo, L., Uwineza, A., Van Essche, R., Rosseels, J., Zabrocki, P., Cameroni, E., Franssens, V., et al. (2017). The yeast protein kinase Sch9 adjusts V-ATPase assembly/disassembly to control pH homeostasis and longevity in response to glucose availability. PLoS Genet. 13, e1006835. [CrossRef]
- Martínez-Muñoz, G.A., and Kane, P. (2008). Vacuolar and plasma membrane proton pumps collaborate to achieve cytosolic pH homeostasis in yeast. J BIOL CHEM 283, 20309-20319. [CrossRef]
- Smardon, A.M., and Kane, P.M. (2014). Loss of vacuolar H+-ATPase activity in organelles signals ubiquitination and endocytosis of the yeast plasma membrane proton pump Pma1p. J BIOL CHEM 289, 32316-32326. [CrossRef]
- Velivela, S.D., and Kane, P.M. (2018). Compensatory Internalization of Pma1 in V-ATPase Mutants in Saccharomyces cerevisiae Requires Calcium- and Glucose-Sensitive Phosphatases. GENETICS 208, 655-672. [CrossRef]
- Tarsio, M., Zheng, H., Smardon, A.M., Martínez-Muñoz, G.A., and Kane, P.M. (2011). Consequences of loss of Vph1 protein-containing vacuolar ATPases (V-ATPases) for overall cellular pH homeostasis. J BIOL CHEM 286, 28089-28096. [CrossRef]
- Cid, A., Perona, R., and Serrano, R. (1987). Replacement of the promoter of the yeast plasma membrane ATPase gene by a galactose-dependent promoter and its physiological consequences. CURR GENET 12, 105-110. [CrossRef]
- Yang, Y., Liu, X., Guo, W., Liu, W., Shao, W., Zhao, J., Li, J., Dong, Q., Ma, L., He, Q., et al. (2022). Testing the polar auxin transport model with a selective plasma membrane H+-ATPase inhibitor. J Integr Plant Biol 64, 1229-1245. [CrossRef]
- Palmgren, M.G., and Christensen, G. (1994). Functional comparisons between plant plasma membrane H+-ATPase isoforms expressed in yeast. J BIOL CHEM 269, 3027-3033. [CrossRef]
- Hatakeyama, R., Kamiya, M., Takahara, T., and Maeda, T. (2010). Endocytosis of the aspartic acid/glutamic acid transporter Dip5 is triggered by substrate-dependent recruitment of the Rsp5 ubiquitin ligase via the arrestin-like protein Aly2. Mol. Cell. Biol. 30, 5598-5607. [CrossRef]
- O'Donnell, A.F., Huang, L., Thorner, J., and Cyert, M.S. (2013). A calcineurin-dependent switch controls the trafficking function of α-arrestin Aly1/Art6. J BIOL CHEM 288, 24063-24080.
- Kahlhofer, J., Leon, S., Teis, D., and Schmidt, O. (2021). The α-arrestin family of ubiquitin ligase adaptors links metabolism with selective endocytosis. Biol. Cell. 113, 183-219. [CrossRef]
- O'Donnell, A.F., Apffel, A., Gardner, R.G., and Cyert, M.S. (2010). Alpha-arrestins Aly1 and Aly2 regulate intracellular trafficking in response to nutrient signaling. Mol. Biol. Cell 21, 3552-3566.
- Becuwe, M., and Léon, S. (2014). Integrated control of transporter endocytosis and recycling by the arrestin-related protein Rod1 and the ubiquitin ligase Rsp5. ELIFE 3.
- Ivashov, V., Zimmer, J., Schwabl, S., Kahlhofer, J., Weys, S., Gstir, R., Jakschitz, T., Kremser, L., Bonn, G.K., Lindner, H., et al. (2020). Complementary α-arrestin-ubiquitin ligase complexes control nutrient transporter endocytosis in response to amino acids. ELIFE 9.
- Wawrzycka, D., Sadlak, J., Maciaszczyk-Dziubinska, E., and Wysocki, R. (2019). Rsp5-dependent endocytosis and degradation of the arsenite transporter Acr3 requires its N-terminal acidic tail as an endocytic sorting signal and arrestin-related ubiquitin-ligase adaptors. BBA-BIOMEMBRANES 1861, 916-925. [CrossRef]
- Hager, N.A., Krasowski, C.J., Mackie, T.D., Kolb, A.R., Needham, P.G., Augustine, A.A., Dempsey, A., Szent-Gyorgyi, C., Bruchez, M.P., Bain, D.J., et al. (2018). Select α-arrestins control cell-surface abundance of the mammalian Kir2.1 potassium channel in a yeast model. J BIOL CHEM 293, 11006-11021.
- Young, B.P., Shin, J.J., Orij, R., Chao, J.T., Li, S.C., Guan, X.L., Khong, A., Jan, E., Wenk, M.R., Prinz, W.A., et al. (2010). Phosphatidic acid is a pH biosensor that links membrane biogenesis to metabolism. Science 329, 1085-1088. [CrossRef]
- Robinson, B.P., Hawbaker, S., Chiang, A., Jordahl, E.M., Anaokar, S., Nikiforov, A., Bowman, R.W., 2nd, Ziegler, P., McAtee, C.K., Patton-Vogt, J., et al. (2022). Alpha-arrestins Aly1/Art6 and Aly2/Art3 regulate trafficking of the glycerophosphoinositol transporter Git1 and impact phospholipid homeostasis. Biol. Cell 114, 3-31.
- Li, S.C., Diakov, T.T., Xu, T., Tarsio, M., Zhu, W., Couoh-Cardel, S., Weisman, L.S., and Kane, P.M. (2014). The signaling lipid PI(3,5)P₂ stabilizes V₁-V(o) sector interactions and activates the V-ATPase. Mol. Biol. Cell 25, 1251-1262.

| NO. | Ver4.0 position | Systemic ID | ortholog in budding yeast | Gene description |
|---|---|---|---|---|
| 1 | V4-P02-12(A12) | SPAC12G12.13c | YNL299W|YOL115W | poly(A) polymerase Cid14 |
| 2 | V4-P02-54(E6) | SPAC13G7.11 | YBR185C | mitochondrial respiratory complex assembly protein (predicted) |
| 3 | V4-P04-33(C9) | SPAC17G8.13c | YBL052C | histone acetyltransferase Mst2 |
| 4 | V4-P04-46(D10) | SPAC1805.01c | YAL017W|YOL045W | serine/threonine protein kinase Ppk6 (predicted) |
| 5 | V4-P06-75(G3) | SPAC22H10.09 | NONE | sequence orphan |
| 6 | V4-P07-62(F2) | SPAC25B8.18 | YKR049C | mitochondrial electron carrier (predicted) |
| 7 | V4-P12-04(A4) | SPAC6G10.08 | YDL066W|YLR174W|YNL009W | isocitrate dehydrogenase Idp1 (predicted) |
| 8 | V4-P13-47(D11) | SPACUNK4.12c | YLR389C | metallopeptidase (predicted) |
| 9 | V4-P17-74(G2) | SPBC18H10.06c | YKL018W | Set1C complex subunit Swd2.1 |
| 10 | V4-P18-15(B3) | SPBC19G7.04 | NONE | HMG box protein |
| 11 | V4-P19-85(H1) | SPBC2D10.04 | YJL084C|YKR021W | arrestin Aly1 related, implicated in endocytosis |
| 12 | V4-P22-41(D5) | SPBC609.02 | YNL128W | phosphatidylinositol-3,4,5-trisphosphate3-phosphatasePtn1 |
| 13 | V4-P25-06(A6) | SPCC1235.09 | YBR103W | Set3 complex subunit Hif2 |
| 14 | V4-P26-63(F3) | SPCC1906.02c | YGL110C | CUE domain protein Cue3 (predicted) |
| 15 | V4-P27-17(B5) | SPCC31H12.05c | YER133W | serine/threonine protein phosphatase Sds21 |
| 16 | V4-P28-81(G9) | SPCC794.10 | YHL012W|YKL035W | UTP-glucose-1-phosphate uridylyltransferase (predicted) |
| 17 | V4-P30-05(A5) | SPAC186.02c | NONE | hydroxyacid dehydrogenase (predicted) |
| 18 | V4-P33-74(G2) | SPBC29A3.21 | NONE | sequence orphan |
| 19 | V4-P34-95(H11) | SPBPB10D8.07c | YPL092W | membrane transporter (predicted) |
| 20 | V4-P35-39(D3) | SPCC162.11c | YNR012W | uridine kinase/uracil phosphoribosyltransferase (predicted) |
| 21 | V4-P35-50(E2) | SPCC16C4.17 | NONE | meiotically upregulated gene Mug123 |
Disclaimer/Publisher’s Note: The statements, opinions and data contained in all publications are solely those of the individual author(s) and contributor(s) and not of MDPI and/or the editor(s). MDPI and/or the editor(s) disclaim responsibility for any injury to people or property resulting from any ideas, methods, instructions or products referred to in the content. |
© 2023 by the authors. Licensee MDPI, Basel, Switzerland. This article is an open access article distributed under the terms and conditions of the Creative Commons Attribution (CC BY) license (http://creativecommons.org/licenses/by/4.0/).
